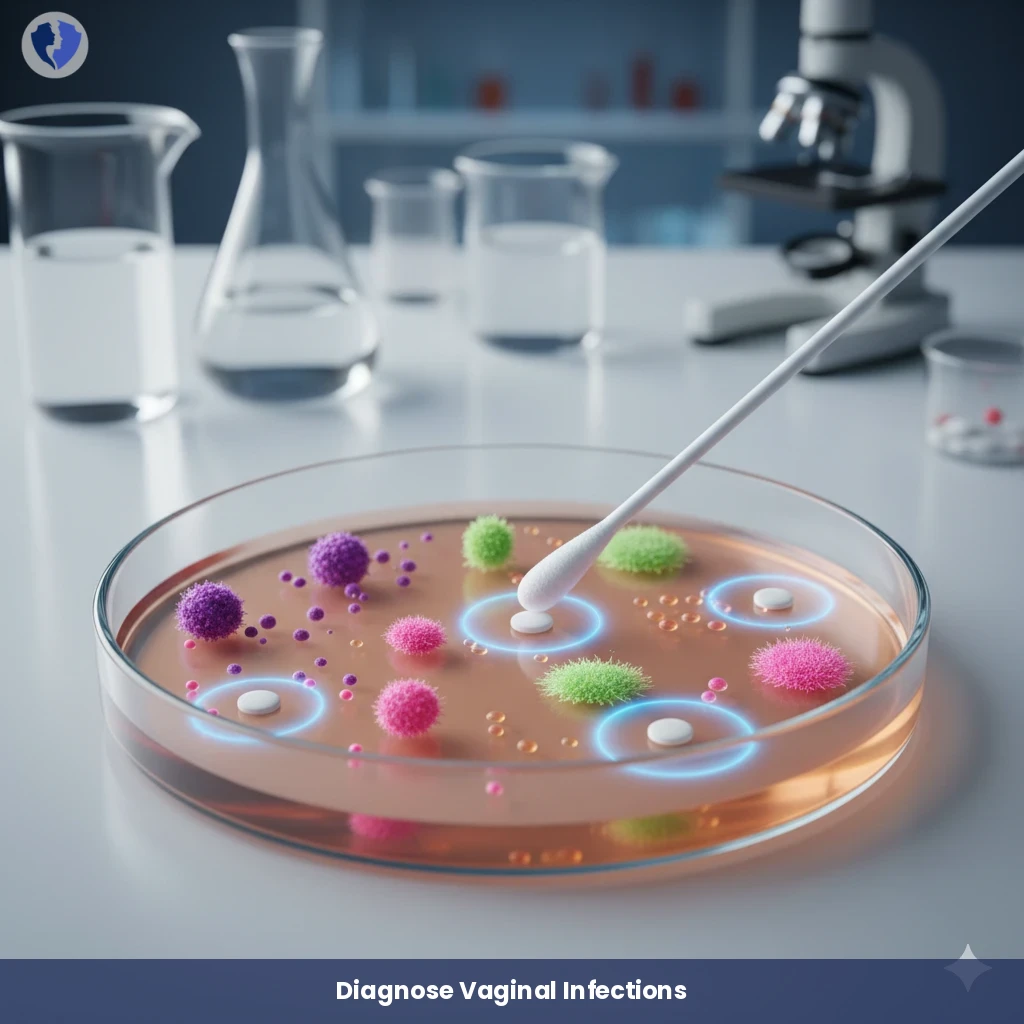
Comprehensive Vaginal Swab Culture - High Vaginal Swab (HVS) Culture and Sensitivity

Service Details
Comprehensive Vaginal Swab Culture - High Vaginal Swab (HVS) Culture and Sensitivity
A microbiological examination in which a sample taken from the upper part of the vagina (high vaginal swab) is cultured on various media (for aerobic bacteria, anaerobic bacteria, and fungi). It aims to isolate and identify pathogenic or overgrown microorganisms (such as Gardnerella vaginalis, Candida spp., and sometimes Trichomonas vaginalis using specific methods) that cause vaginitis. The test includes antimicrobial susceptibility testing to determine the sensitivity of the microorganism to antibiotics/antifungals in order to guide the most appropriate treatment.